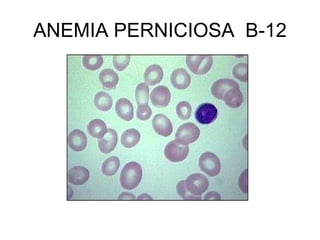
ANEMIA PERNICIOSA B-12

Las vitaminas son compuestos químicos que no son sintetizados por el cuerpo pero son esenciales para la vida. Funcionan como catalizadores en reacciones bioquímicas liberando energía. Existen vitaminas liposolubles como A, D, E y K, y vitaminas hidrosolubles como los grupos B y la C. Las deficiencias de vitaminas pueden causar enfermedades como ceguera nocturna por falta de A, raquitismo por falta de D, beriberi por falta de B1 y escorbuto por falta de C.